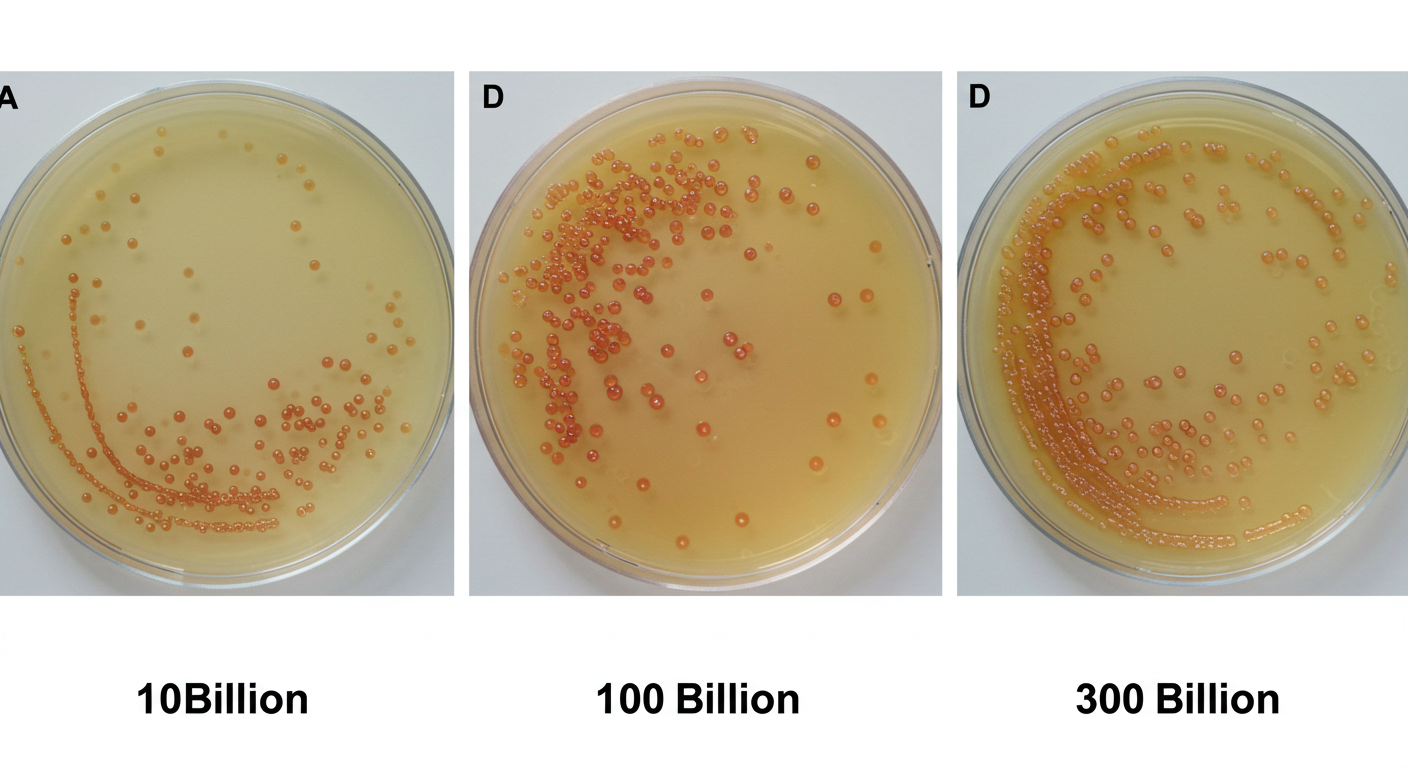

오늘, 2025년 5월 16일 금요일! 치킨 마니아라면 절대 놓칠 수 없는 대박 소식이 있어요. 바로 BBQ에서 전국 매장을 대상으로 '반마리 추가' 이벤트를 단 하루 진행한다는 사실! 주말을 앞둔 오늘, 특별한 치킨 혜택으로 더욱 풍성한 저녁을 만들어보시는 건 어떠세요? 이 기회, 오늘이 지나면 끝이니 서두르세요!
1. 비비큐 반마리 추가, 어떤 이벤트인가요?
오늘 단 하루 진행되는 비비큐 반마리 추가 이벤트는 BBQ의 인기 메뉴를 주문하면 치킨 반 마리를 더! 드리는 파격적인 행사예요. 전국 BBQ 오프라인 매장은 물론, 공식 앱이나 배달앱을 통해서도 동일한 혜택을 받을 수 있답니다. 평소보다 훨씬 넉넉한 양의 치킨을 즐길 수 있는 절호의 찬스, 오늘 저녁은 BBQ 치킨으로 결정해야겠죠?
2. 참여방법 간단! 온라인&오프라인 모두 OK
이번 비비큐 반마리 추가 이벤트 참여 방법은 정말 간단해요. 가까운 BBQ 매장에 직접 방문하시거나, BBQ 공식 앱 또는 즐겨 사용하시는 배달앱을 통해 주문하시면 된답니다. BBQ의 대표 메뉴인 황금올리브치킨부터 자메이카통다리구이, 치즐링 등 다양한 인기 메뉴에 반마리 추가 혜택이 적용되니, 취향 따라 골라 즐기기만 하면 돼요. 집에서도 편하게 주문하고 푸짐하게 즐겨보세요!
3. 반마리 더! 풍성한 혜택 즐기기
비비큐 반마리 추가 이벤트의 가장 큰 매력은 뭐니 뭐니 해도 같은 가격에 더 많은 치킨을 맛볼 수 있다는 점이죠! 친구들과 함께, 가족들과 함께, 오늘 저녁은 치킨 파티를 열어도 부족함이 없을 거예요. 일부 매장에서는 한정판 사이드 메뉴 증정이나 포인트 적립 같은 추가 혜택도 있다고 하니, 금상첨화랍니다!
4. 비비큐 반마리 추가, 오늘 저녁 치킨 파티 각!
오늘 저녁, 비비큐 반마리 추가 이벤트 소식에 많은 분들이 벌써부터 들썩이고 있어요! 일부 매장에서는 현장 분위기를 더욱 뜨겁게 달굴 다양한 이벤트도 함께 진행 중이라고 하는데요. 맛있는 치킨도 먹고, 즐거운 이벤트도 참여하면 금요일 저녁이 더욱 특별해지겠죠? 인기 메뉴는 조기 품절될 수 있으니, 지금 바로 주문을 서두르세요! 오늘 같은 날은 그야말로 '치킨 파티 각'이랍니다!
5. 참여 전 꿀팁! 더 알차게 즐기자
비비큐 반마리 추가 이벤트를 더욱 알차게 즐기고 싶다면, 몇 가지 꿀팁을 활용해보세요! BBQ 공식 앱에서 혹시 다운로드할 수 있는 쿠폰이 있는지, 혹은 포인트 적립 이벤트가 함께 진행 중인지 미리 확인하면 더욱 좋아요. SNS 인증샷 이벤트에 참여하면 추가 경품의 행운도 노려볼 수 있으니, 다양한 채널을 통해 이벤트 정보를 확인하고 참여해보세요!
오늘 단 하루, BBQ가 준비한 반마리 추가 이벤트! 망설이면 늦어요. 지금 바로 가까운 BBQ 매장이나 앱을 통해 주문하고, 행복 가득한 금요일 저녁을 만끽하세요!